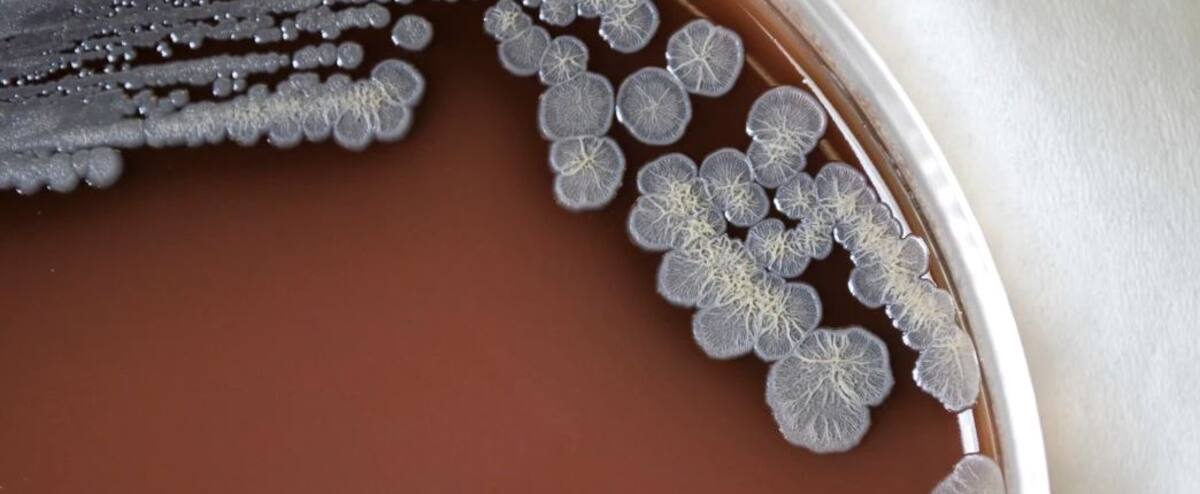
A bacteria that causes a serious infectious disease has been discovered in the United States A bacteria that causes a serious infectious disease has been discovered in the United States

U.S. health officials announced Wednesday that soil and water samples taken from Mississippi have contained bacteria that cause a rare but serious disease called melioidosis.
• Read more: Will the proliferation of STBBIs soon be a thing of the past?
Due to this, the authorities have warned the country’s doctors and asked the patients to be careful as there is a possibility of this disease.
Two individuals living in the southern United States, in the Gulf of Mexico region, were separately diagnosed with the disease in 2020 and 2022, prompting the Centers for Disease Control and Prevention (CDC) to take the virus into and near their homes.
Three samples, soil and puddles, were tested for the presence of the bacterium (Burkholderia pseudomallei).
Regardless, the CDC considers the risk to the general public to be “very low.” They are currently conducting research to determine how widespread the bacteria is in the environment.
Symptoms of melioidosis can be widespread, such as fever, joint pain, or headache. It can cause pneumonia, abscess formation or infections. Globally, melioidosis is fatal in 10–50% of cases.
Highly vulnerable people living in Mississippi are advised to avoid contact with muddy water, protect their wounds or wear waterproof boots and gloves while gardening.
About 12 cases of melioidosis are diagnosed each year in the United States, mostly in people who have traveled to countries where the bacterium is endemic, particularly tropical regions. There have also been other cases of contamination of products from these countries.